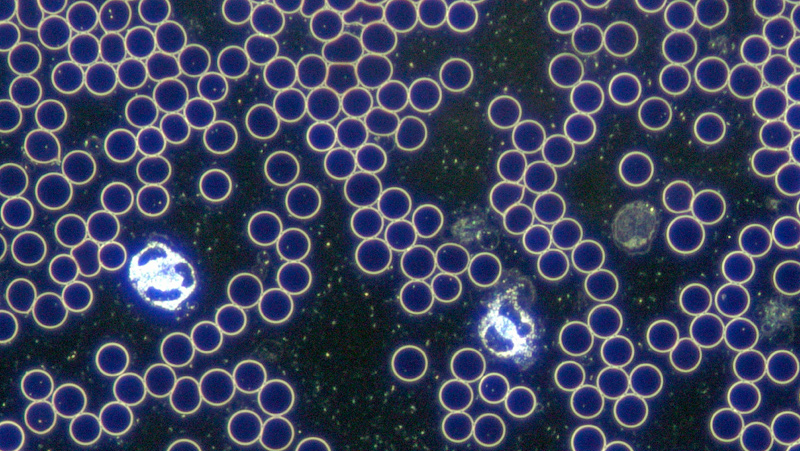

De Levend Bloed Analyse (LBA) is een diagnostische onderzoeksmethode waarbij gekeken wordt naar de kwaliteit van verschillende elementen van het bloed. Er wordt gekeken naar de vorm en de activiteit van de bloedcellen. In onze praktijk hanteren wij voornamelijk de donkerveld microscopie volgens de methode van Prof. Dr. Gunther Enderlein.
Levend Bloed Analyse vormt een interessante aanvulling op de klassieke bloedanalyse. De activiteit van de witte bloedcellen, de aanwezigheid van andere partikels, eiwitstoringen, vrije radicaalactiviteit en de kwaliteit van het omgevingsmilieu van de cellen kunnen waargenomen worden. De afwijkingen in de vorm van bijvoorbeeld de witte bloedcellen of de levendigheid van de cellen kunnen een aanwijzing geven naar de oorzaak van de klacht. Zo kijken we bijvoorbeeld naar de vorm van de rode bloedcellen, wat kan aangeven hoe het gesteld is met de werking van organen zoals de lever en de milt. Ook de mate van activiteit van de witte bloedcellen (en dus de activiteit van het immuunsysteem) kunnen we afzien in dezelfde druppel bloed. Tevens stellen we vast of er in het bloed elementen aanwezig zijn die daar niet in thuis horen, zoals bacteriën, parasieten, mycolasma’s en de mogelijke gevolgen van een schimmelinfectie zoals aspergillus en candida. Dit onderzoek is dus uitermate geschikt voor onder andere de detectie van een mogelijke schimmelbelasting, intracellulaire infecties, belastingen en afwijkingen aan het immuunsysteem enz.
Het is mogelijk om de verschillende bloedbestanddelen duidelijk van elkaar te onderscheiden zoals de rode en de witte bloedcellen, fibrinedraden en afvalstoffen. Het is een hele andere kijk op het bloed met veelal verrassende uitkomsten. Wat een standaard bloedonderzoek niet laat zien, kan wel aan het licht komen bij een Levend Bloed Analyse.
Door middel van één klein prikje en een druppel bloed kan het bloed worden geanalyseerd. LBA is een methode om vooral de kwaliteit van het bloed in levende toestand te bestuderen. Het is verbazingwekkend hoeveel verstoringen er te zien zijn. Deze verstoringen kunnen leiden tot allerlei klachten (bijv. Chronische vermoeidheid, darmproblemen, ontstekingen, detoxificatie problemen, enz.). Doordat deze klachten bij een normaal (regulier) bloedonderzoek weinig of geen (kwantitatieve) afwijkingen vertonen, kan er aan de klachten niets gedaan worden. Wij kijken er natuurlijk anders naar!
De Levend Bloed Analyse geeft goede informatie die nuttig is bij het opstellen van een behandelplan.